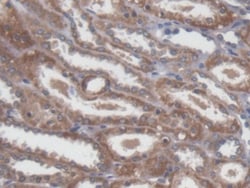
Invitrogen NME5 Polyclonal Antibody, Invitrogen 20 &mu;L | Buy Online | Invitrogen&trade; | Fisher Scientific

missing translation for 'onlineSavingsMsg'
Learn More
Learn More
Invitrogen™ NME5 Polyclonal Antibody, Invitrogen™
Descripción
Does not seem to have NDK kinase activity. Confers protection from cell death by Bax and alters the cellular levels of several antioxidant enzymes including Gpx5. May play a role in spermiogenesis by increasing the ability of late-stage spermatids to eliminate reactive oxygen species.

Especificaciones
Especificaciones
| Antígeno | NME5 |
| Aplicaciones | Immunohistochemistry (Paraffin), Western Blot, Immunocytochemistry |
| Clasificación | Polyclonal |
| Concentración | 0.5 mg/mL |
| Conjugado | Unconjugated |
| Formulación | PBS with 50% glycerol and 0.05% Proclin 300; pH 7.4 |
| génica | NME5 |
| N.º de referencia del gen | P56597, Q99MH5 |
| Alias de gen | 1700019D05Rik; expressed in non-metastatic cells 5; inhibitor of p53-induced apoptosis-beta; IPIA-beta; NDK-H 5; NDP kinase homolog 5; NM23H5; NM23-H5; nm23-M5; NME/NM23 family member 5; NME5; non-metastatic cells 5 protein expressed in; non-metastatic cells 5, protein expressed in (nucleoside-diphosphate kinase); nucleoside diphosphate kinase homolog 5; radial spoke 23 homolog; RSPH23; testis-specific nm23 homolog |
| Símbolos de los genes | NME5 |
| Mostrar más |
Título del producto
Al hacer clic en Enviar, acepta que Fisher Scientific se ponga en contacto con usted en relación con los comentarios que ha proporcionado en este formulario. No compartiremos su información para ningún otro fin. Toda la información de contacto proporcionada se mantendrá de acuerdo con nuestra Política de Privacidad. Política de privacidad.
¿Detecta una oportunidad de mejora?